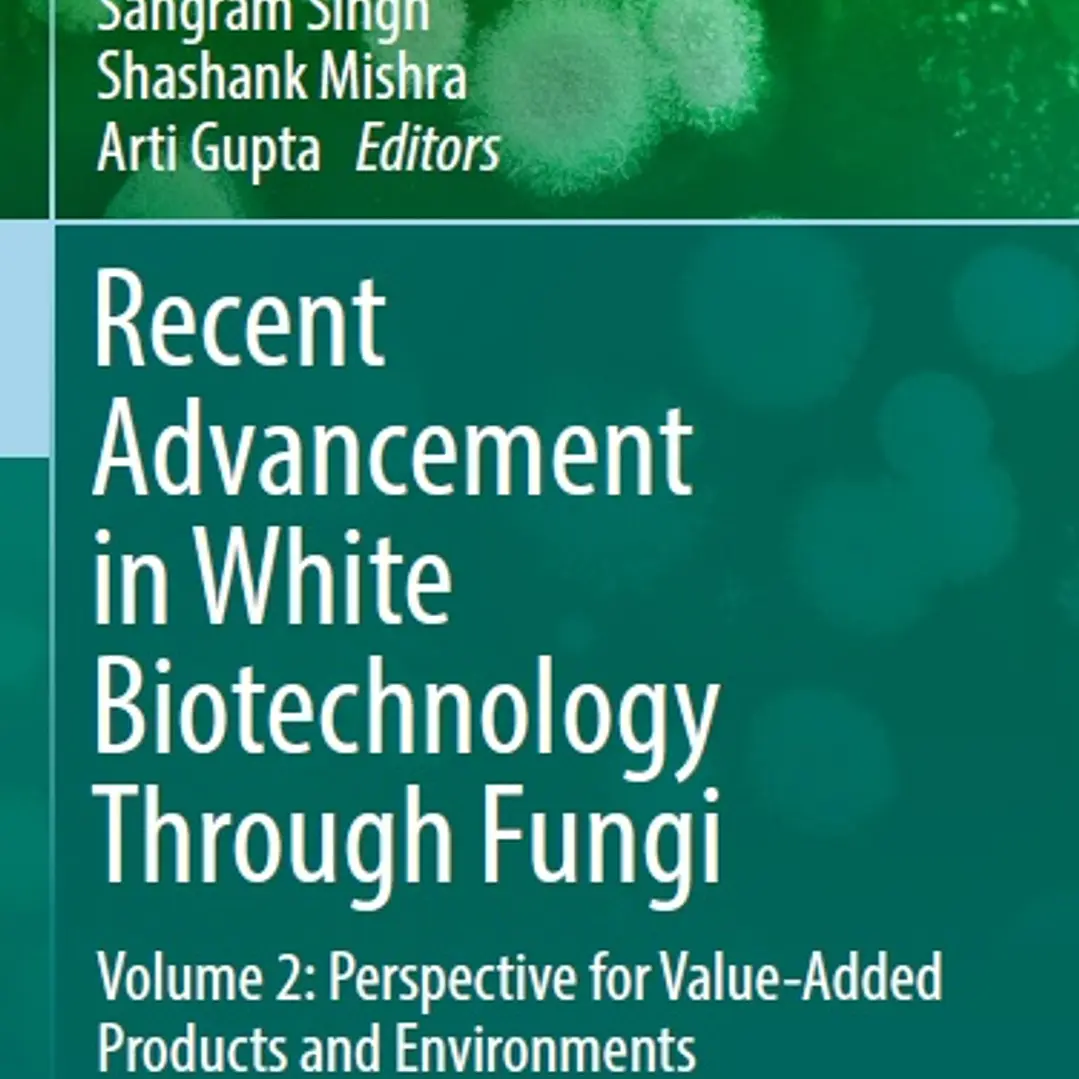

Description
White biotechnology is industrial biotechnology dealing with various biotech products through applications of microbes. The first large-scale industrial applications of modern biotechnology have been made in the areas of food and animal feed producti

Reviews
There are no reviews yet.